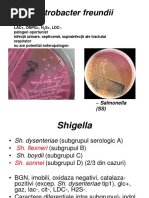

0% au considerat acest document util (0 voturi)
300 vizualizări4 paginiYERSINIA
Documentul prezintă informații despre genurile Yersinia și Shigella, inclusiv speciile patogene pentru om, caracteristicile morfologice, de cultură și biochimice, structura antigenică, rezistența în mediu, mecanismele de patogenitate și afecțiunile produse.
Încărcat de
Luminita MarinaDrepturi de autor
© © All Rights Reserved
Respectăm cu strictețe drepturile privind conținutul. Dacă suspectați că acesta este conținutul dumneavoastră, reclamați-l aici.
Formate disponibile
Descărcați ca DOCX, PDF, TXT sau citiți online pe Scribd
0% au considerat acest document util (0 voturi)
300 vizualizări4 paginiYERSINIA
Documentul prezintă informații despre genurile Yersinia și Shigella, inclusiv speciile patogene pentru om, caracteristicile morfologice, de cultură și biochimice, structura antigenică, rezistența în mediu, mecanismele de patogenitate și afecțiunile produse.
Încărcat de
Luminita MarinaDrepturi de autor
© © All Rights Reserved
Respectăm cu strictețe drepturile privind conținutul. Dacă suspectați că acesta este conținutul dumneavoastră, reclamați-l aici.
Formate disponibile
Descărcați ca DOCX, PDF, TXT sau citiți online pe Scribd